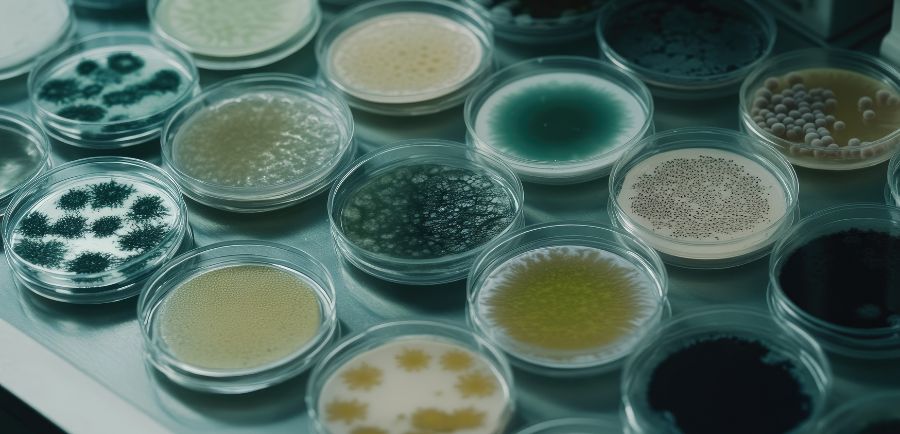

The paints, coatings, and construction materials industries rely heavily on effective preservation technologies to ensure product stability, performance, and safety. Water-based formulations in particular require robust protection against microbial contamination during manufacturing, storage, and application. Onnovo Group has emerged as a technically focused global provider of preservation solutions and performance additives designed specifically for these industries.
Through strong scientific expertise, industry experience, and strategic partnerships, Onnovo supports manufacturers with advanced antimicrobial technologies, formulation guidance, and reliable supply capabilities.